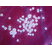

Marke:
Leonardi
Größe:
80x80
Farbe:
Lila
Handarbeit:
nein
Jahreszeit:
ganzjährig
m/w:
Damen
Zustand:
gebraucht
Zustandsbeschreibung
Hervorragend erhalten.
Artikelbeschreibung
Ohne Flecken oder Beschädigungen.
Schlagworte
k.A.
Diese Artikel könnten Sie auch interessieren
Tickets:
3